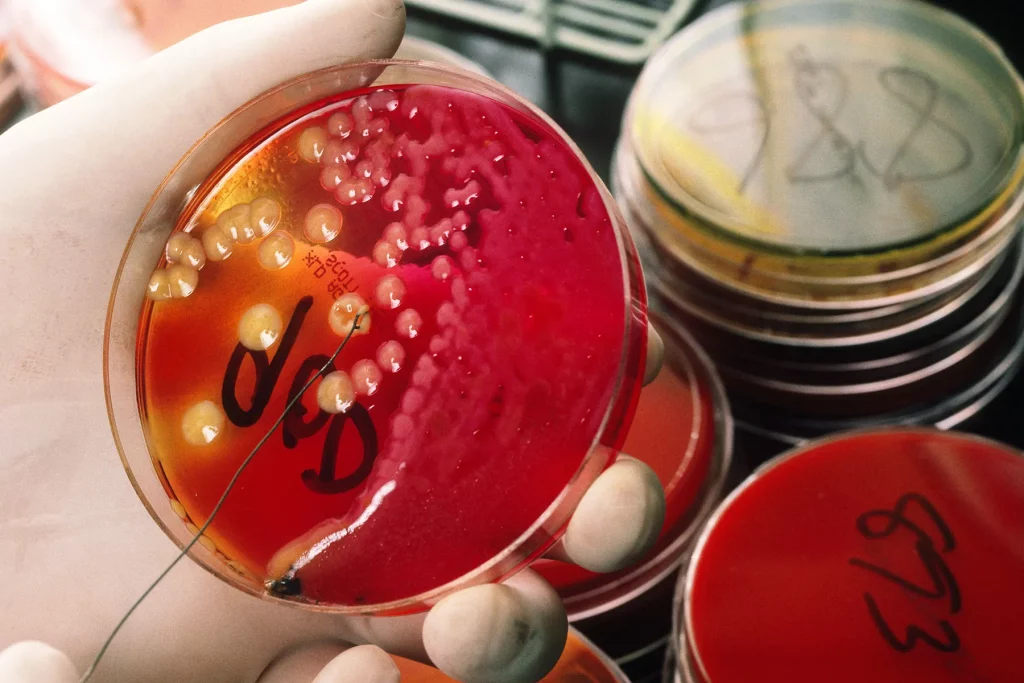
Gut Check: The Real Reason You Avoid That At-Home Stool Test

![]()
Feb. 16, 2023 – Many people, including 20% of Americans ages 50 to 75, are behind on colorectal cancer screenings – even though do-it-yourself tests let you collect a sample easily and privately in your own home.
One possible explanation: A lot of people convince themselves they don’t need it.
Psychologists call this “defensive information processing” – adopting beliefs to lessen fears of a threat. And new research in the journal Cancer suggests it could be a key reason that some people don’t get recommended colorectal cancer screenings.
Researchers surveyed 2,600 people in Ireland who had been invited to complete at-home stool tests to screen for colorectal cancer a few years prior.
Compared to people who took the test, those who refused it scored higher on measures of defensiveness. Examples included avoidance, denial, assuming the risk of colorectal cancer didn’t apply, or arguing against the evidence for the test.
People were especially unlikely to complete the stool test if they scored high on two behaviors:
- Denying the urgency of needing to be tested. They assumed they could wait until they were less busy or when another, better test might come along.
- Self-exemption, meaning they assumed they didn’t need a test because they had regular bowel movements, lived a healthy lifestyle, or ate plenty of vegetables.
“These arguments underlie a lack of awareness of how colorectal cancer develops,” says study author Nicholas Clarke, PhD, a postdoctoral researcher in psychology at Dublin City University in Ireland. “Bowel cancer can take 10 years to begin to show any signs or symptoms in a person.”
By the time symptoms occur, the disease is often at a later, harder-to-treat stage. According to the CDC, almost 88% of adults diagnosed with colorectal cancer at an early stage live for 5 years or more, compared to only 16% of those diagnosed with late-stage cancer.
In this study, people received a mailed invitation to do their screening. In a different context, other defensive behaviors might occur. In the U.S., for example, when a health care provider broaches the subject of screening, people “may engage more in counter-arguing or opting out,” says Clarke. “We do need further research in this area to understand how defensive reactions may differ depending on the context in which the test is offered.”
There’s a social component too – in the study, people in more economically deprived areas scored higher on defensiveness and were less likely to take part in screening.
“The need to carry out further research and design evidence-based interventions which tackle these disparities is key to improving colorectal cancer screening uptake rates,” says Clarke.
This is particularly important for men, as men have higher rates of colorectal cancer than women and yet are less likely to get screening, says Clarke.
So, what can you do if your gut reaction is to decline a test?
“I think if a person receives an invitation to be screened and initially has a negative reaction, or thinks, ‘No, I’m not doing that,’ or ‘I don’t need that,’ they should reflect on why they have had that initial reaction,” says Clarke. “If a person recognizes that, it would be useful to look for trustworthy information, such as on the American Cancer Society or Irish Cancer Society websites.” Talking to your doctor can help you make the right choice for you.
As a society, we can do more to spread the word, too. That means raising public awareness of colorectal cancer, how it develops, and how long a person can have it without symptoms, says Clarke. “I believe if people were aware of the trajectory of the disease, they would be less defensive to the invitation to be screened.”